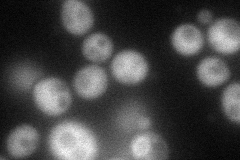
YPL144W
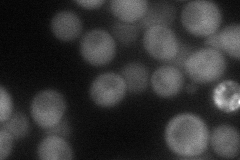
YPL144W
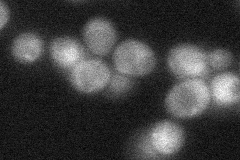
YPL144W
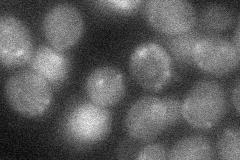
YPL144W
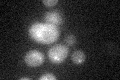
YPL144W

View description
Component of a heterodimeric Poc4p-Irc25p chaperone involved in assembly of alpha subunits into the 20S proteasome; may regulate formation of proteasome isoforms with alternative subunits under different conditions
Localization:
Intensity:
Fold change:
Significance:
-
C’ GFP library in SD

below threshold17.04 -
N' NOP1pr-GFP in SD
cytosol76.4573 -
N' TEF2pr-mCherry in SD
cytosol46.2371 -
N' NATIVEpr-GFP in SD
cytosol32.564 -
N' TEF2pr-VC and Cyto-VN in SD
below threshold26.8592 -
C’ GFP library in SD+DTT
cytosol16.550.97No -
C’ GFP library in SD+H2O2

cytosol14.810.86No -
C’ GFP library in Starvation Media

cytosol16.60.97No -
C’ GFP library on the background of Pup2-DaMP

below threshold -
C’ GFP library on the background of CCT mutant

below threshold15.60910.9157No
